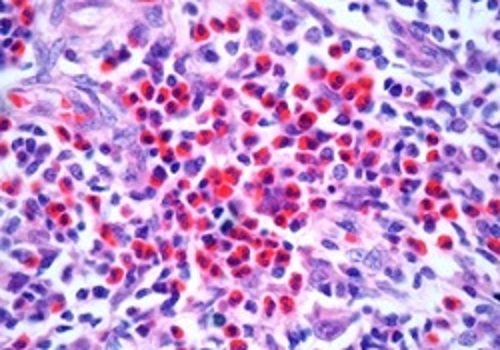

508-е заседание Петербургского онкологического научного общества
Дата публикации: 31.03.2016
8 апреля 2016 г. в отеле "Коринтия Санкт-Петербург" (Санкт-Петербург, Невский пр., 57) пройдёт 508 заседание Петербургского онкологического научного общества. Тема заседания: "Современный взгляд на лечение больных лимфомой Ходжкина". Начало регистрации участников с 14.30.
Для участия в мероприятии пройдите регистрацию
Онлайн трансляцию заседания можно посмотреть по ссылке: http://videomed.pro/lymph2016. Все участники смогут задать свои вопросы через онлайн-чат.
В программе:
15.00-15.15 Вступительное слово: проф. Беляев А.М., проф. Поддубная И.В., проф. Афанасьев Б.В.
15.15-15.45 Риск-адаптированные стратегии лечения пациентов с лимфомой Ходжкина кмн Алексеев С.М., ФГБУ НИИ онкологии им Н.Н. Петрова
15.45-16.15 Рецидивы и резистентные формы лимфомы Ходжкина. Современный взгляд на состояние проблемы проф. Афанасьев Б.В., ПСБГМУ им. акад. И.П.Павлова
16.15-16.45 Место и роль лучевой терапии в лечении лимфомы Ходжкина. проф. Ильин Н.В., ФГБУ РНЦРХТ
16.45-17.00 Подведение итогов проф. Беляев А.М., проф. Поддубная И.В., проф. Афанасьев Б.В.
17.00-18.00 Фуршет.
Телефон для справок: (812) 439-95-55.
Факс: (812) 596-89-47.
E-mail: oncl@rion.spb.ru
